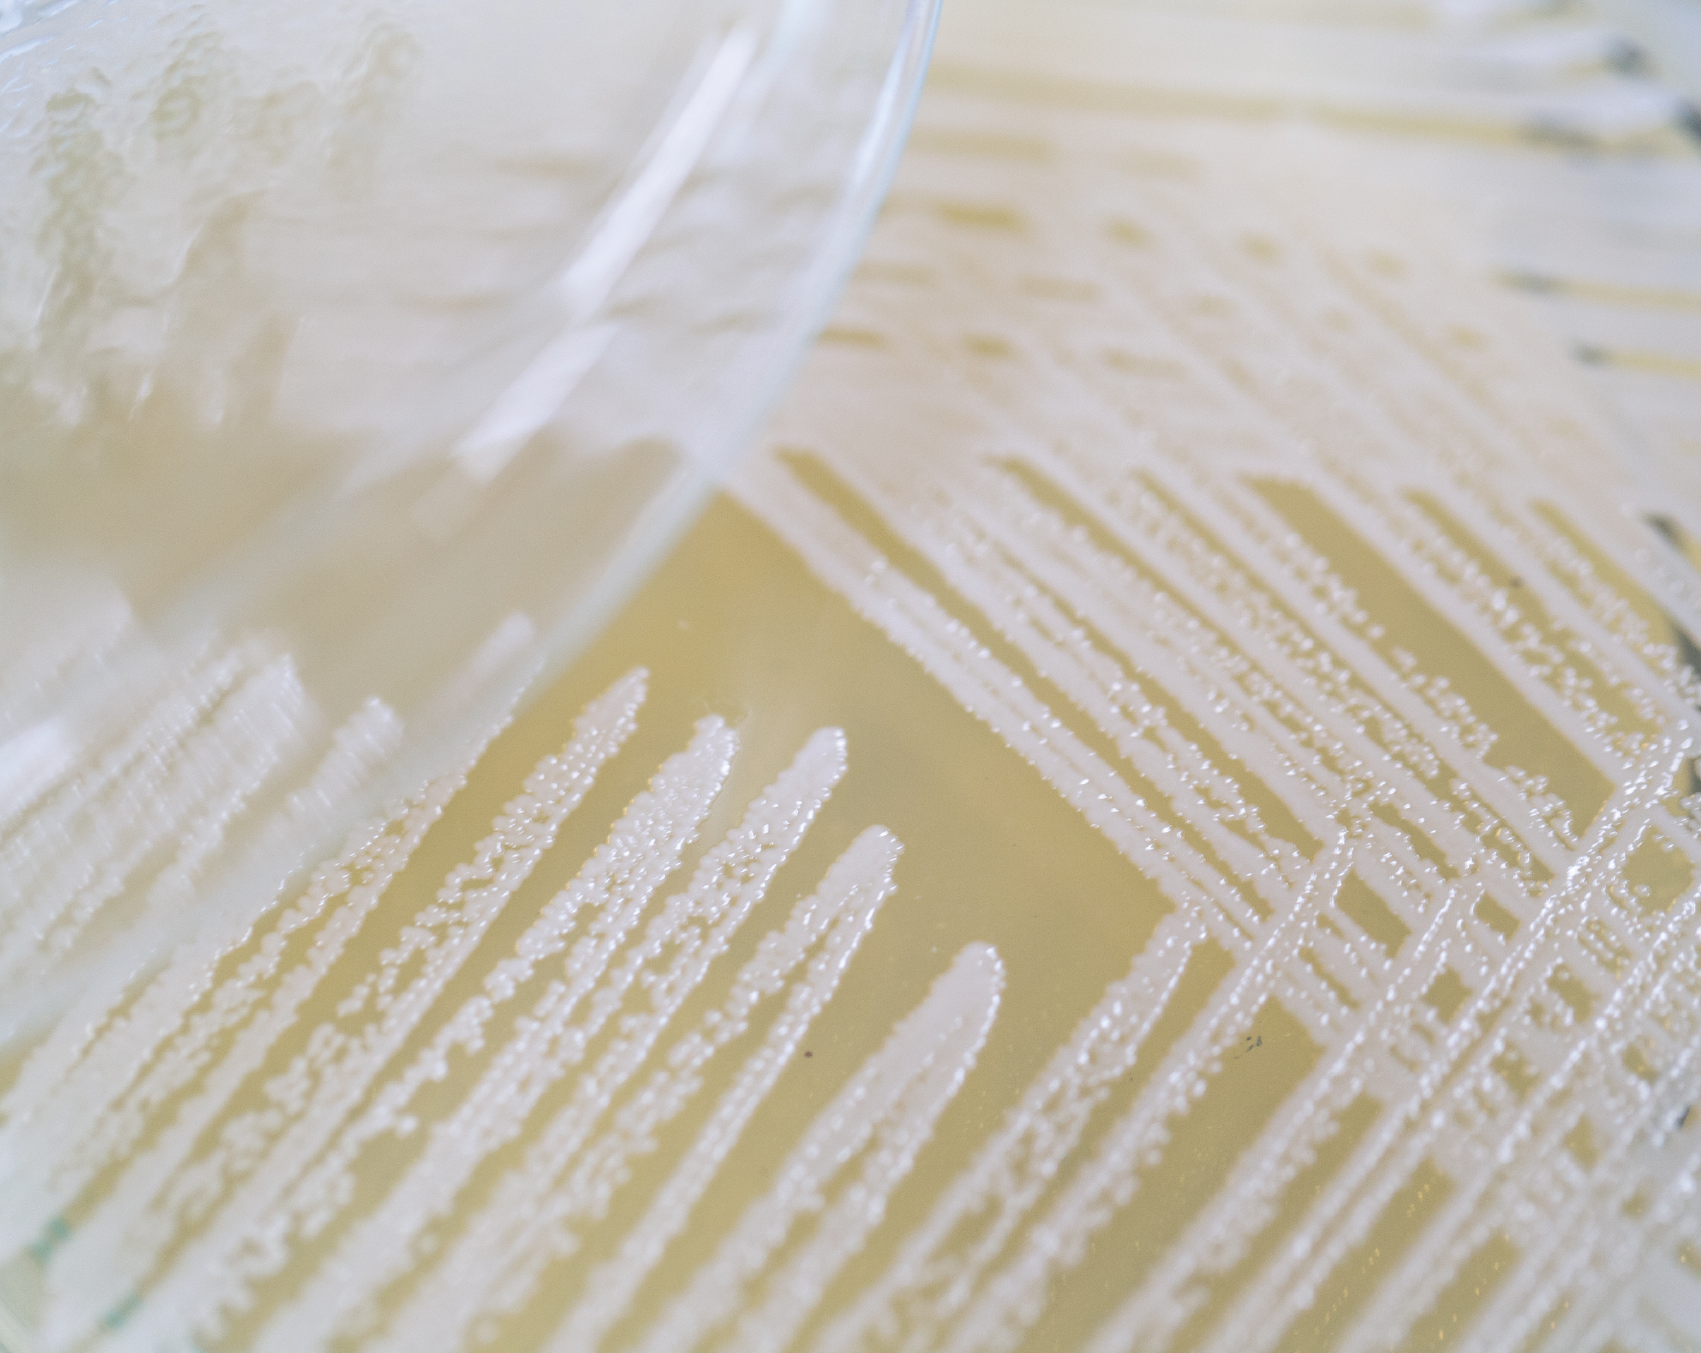

Daydream Crème
Daily Lightweight Moisturizer
$19.99
Pairs well with
Key Ingredients
SOFT BISOUS
Plumping Lip Balm
Plumping Lip Balm
Formulated with hydrators, butters, and peptides that soothe and repair chapped lips


Award WINNER
Alpha-bet Élixir
Multi-vitamin Soothing Oil
Multi-vitamin Soothing Oil
A vitamin-packed face oil that smooths, calms, and brightens skin


Award Winner
BARE LUMIÈRE
Barrier Repair Cream
Barrier Repair Cream
A 5-in-1 moisturizer that improves skin barrier within one day


NEW
Le Bounce
Plumping Skincare Set$62.97
Plumping Skincare Set
A trio of skin-firming essentials for plumper, more bouncy skin.